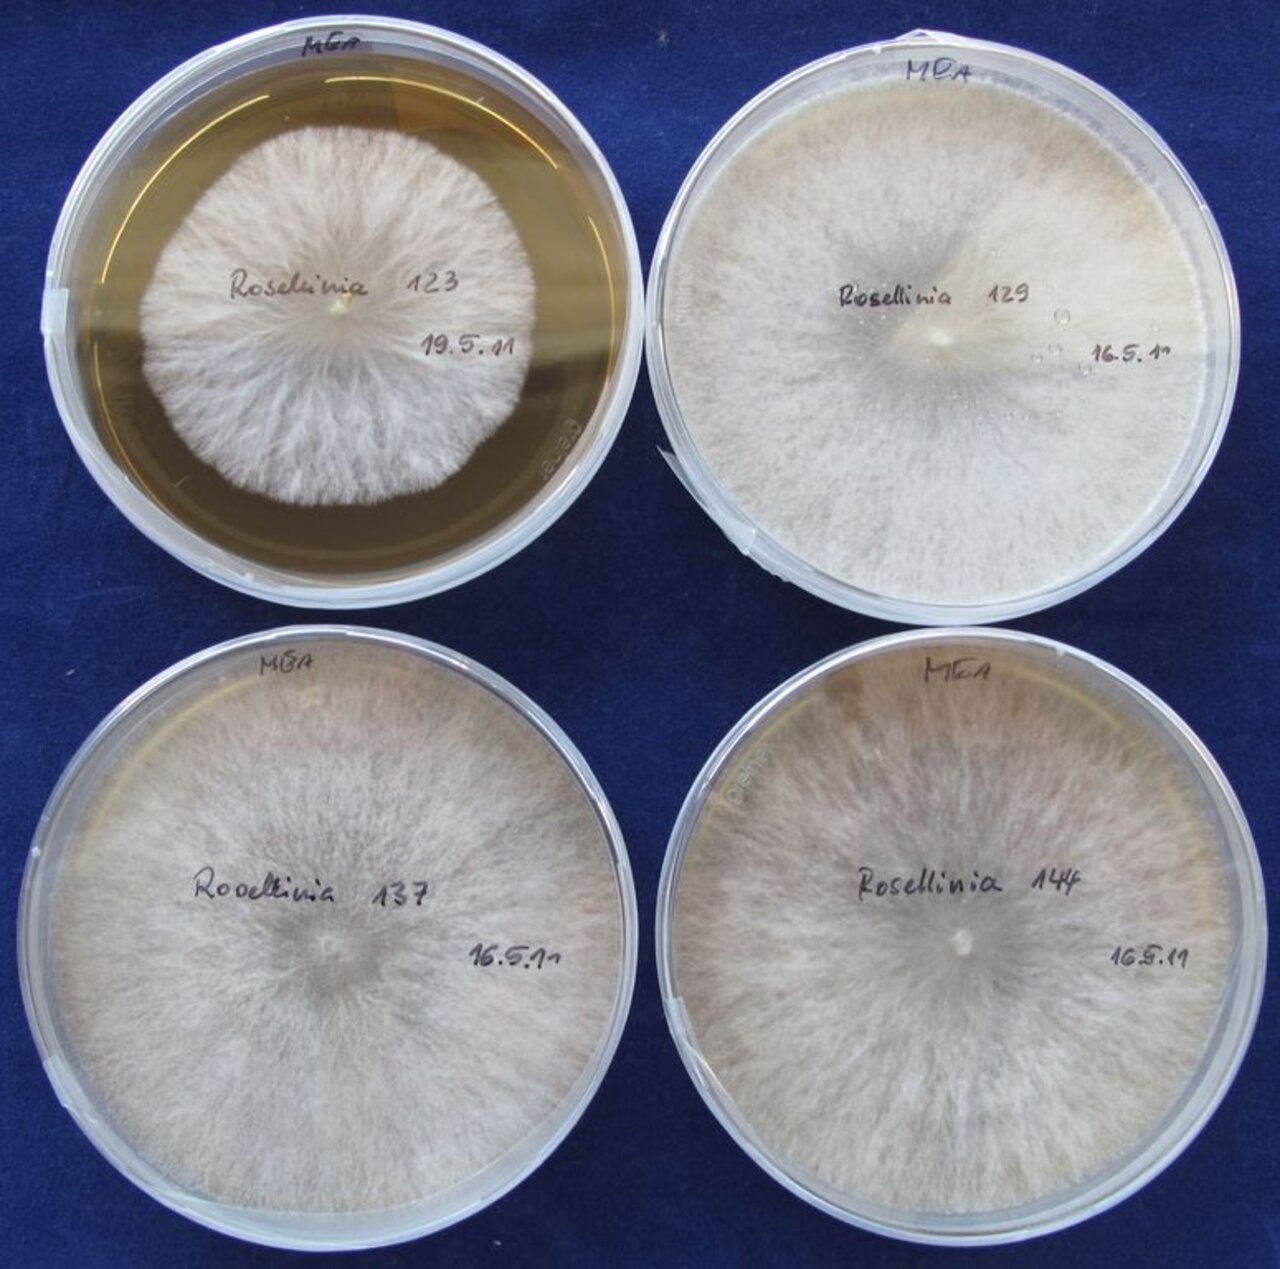

Projekt
Mykotoxinbildende Pilze
Untersuchung von PF1022A produzierenden Mikroorganismen, die saprophytisch und endophytisch bei forstlichen Baumarten vorkommen
Pilzliche Organismen, die in bzw. auf den verschiedensten Forstbaumarten in bewirtschafteten Beständen und in natürlichen Waldstandorten vorkommen, produzieren verschiedene zyklische Depsipeptide, insbesondere das zyklische Oktadepsipeptid PF1022A. Diese Stoffgruppe besitzt anthelmintische bzw. nematizide Wirkungen. Alle bisher gefundenen Pilze mit dieser Eigenschaft gehören zur Gruppe der Xylariaceen. Zielstellung des Projektes ist die Verbesserung der Metabolitbildung der bisher selektierten Stämme sowie Gewinnung weiterer Stämme
Hintergrund und Zielsetzung
Gewinnung und Identifizierung von PF1022A-produzierenden Stämmen
Vorgehensweise
Nachweis der Metabolitproduktion
Thünen-Ansprechperson

Beteiligte externe Thünen-Partner
-
Bundesanstalt für Materialforschung
(Berlin, Deutschland)
Geldgeber
-
Bayer Crop Science
(international, privat)
Zeitraum
11.2011 - 6.2014
Weitere Projektdaten
Projektstatus:
abgeschlossen